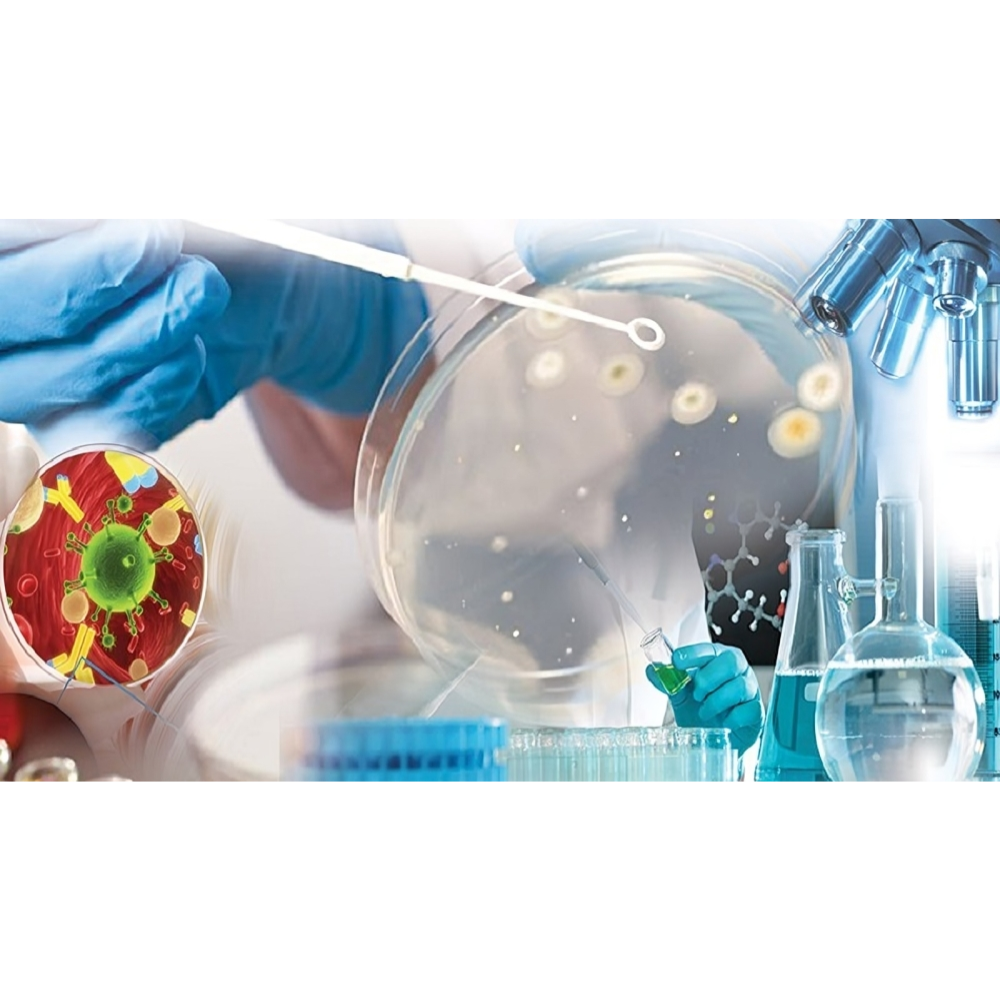

میکروبیولوژی دارویی: تولید آنتیبیوتیک، ویتامین، آنزیم
مقدمه و اهمیت میکروبیولوژی دارویی
میکروبیولوژی دارویی یکی از شاخههای حیاتی و پیشرفته علوم زیستی است که نقش مستقیمی در سلامت انسان، توسعه داروهای نوین و بهبود کیفیت زندگی دارد. در سطح علمی، این شاخه بر روی کاربرد میکروارگانیسمها برای تولید مواد دارویی با کارایی بالا تمرکز میکند؛ موادی که شامل آنتیبیوتیکها، ویتامینها، آنزیمها و دیگر متابولیتهای بیولوژیک هستند. میکروارگانیسمها، اعم از باکتریها، قارچها، جلبکها و حتی همزیستهای حشرات، به عنوان کارخانههای زیستی طبیعی عمل میکنند و قادرند ترکیباتی را تولید کنند که سنتز شیمیایی آنها دشوار یا حتی غیرممکن است.
تاریخچه میکروبیولوژی دارویی به بیش از یک قرن پیش بازمیگردد، زمانی که الکساندر فلمینگ در سال ۱۹۲۸ با کشف پنیسیلین، مسیر جدیدی در تولید آنتیبیوتیکها و درمان بیماریهای عفونی ایجاد کرد. این کشف نه تنها انقلابی در پزشکی ایجاد کرد، بلکه اهمیت استفاده از میکروارگانیسمها را در تولید داروهای پیچیده روشن ساخت. از آن زمان تا به امروز، پژوهشگران با استفاده از روشهای پیشرفته بیوتکنولوژی و مهندسی متابولیکی، توانستهاند تولید انواع داروهای ضدباکتری، ضدقارچ و حتی داروهای ضدسرطان را با میکروارگانیسمها به سطح صنعتی برسانند.
نقش میکروارگانیسمها در سلامت و صنعت دارویی بسیار گسترده است. این موجودات کوچک قادرند ترکیبات پیچیدهای تولید کنند که نه تنها مستقیماً برای درمان بیماریها کاربرد دارند، بلکه به عنوان پیشداروها، کوفاکتورهای آنزیمی و مکملهای تغذیهای نیز استفاده میشوند. برای مثال، برخی باکتریها و قارچها قادرند ویتامینهای گروه B و اسیدهای آمینه ضروری را در مقیاس صنعتی تولید کنند، در حالی که جلبکها و سیانوباکتریها منابع غنی از آنتیاکسیدانها و متابولیتهای دارویی طبیعی هستند. این ویژگیها باعث شده است که میکروبیولوژی دارویی نه تنها در داروسازی، بلکه در صنایع تغذیهای، کشاورزی و حتی بیومواد نیز کاربرد گسترده پیدا کند.
از دیدگاه علمی و تحقیقاتی، میکروبیولوژی دارویی یک حوزه پویا و بینرشتهای است. این علم نیازمند ترکیب دانش میکروبشناسی، بیوشیمی، بیوتکنولوژی و ژنتیک میباشد تا بتوان مسیرهای متابولیکی میکروارگانیسمها را شناسایی و بهینهسازی کرد. امروزه با استفاده از فناوریهایی مانند مهندسی ژنتیک، بیوراکتورها، کشت سلولی و شبیهسازیهای متابولیک، تولید داروها با کیفیت بالا، خلوص مناسب و بهرهوری اقتصادی به مراتب افزایش یافته است.
علاوه بر تولید دارو، میکروبیولوژی دارویی به توسعه داروهای نوین و درمانهای شخصیسازی شده کمک میکند. به عنوان مثال، کشف مسیرهای جدید سنتز آنتیبیوتیکها و ترکیبات ضدسرطان توسط میکروارگانیسمها، امکان طراحی داروهای هدفمند با عوارض جانبی کمتر را فراهم میآورد. همچنین، این علم زمینه را برای تولید داروهای طبیعی، بیواکتیو و ترکیبات نانویی آماده میکند که در آینده نزدیک میتوانند جایگزین بسیاری از داروهای سنتزی شوند.
اهمیت اقتصادی و صنعتی میکروبیولوژی دارویی نیز قابل توجه است. با توجه به رشد بازار جهانی داروهای بیولوژیک و نیاز مداوم به محصولات با کیفیت و مقرونبهصرفه، استفاده از میکروارگانیسمها به عنوان کارخانههای زیستی، راهکاری پایدار و اقتصادی محسوب میشود. این رویکرد نه تنها هزینه تولید را کاهش میدهد، بلکه به کاهش استفاده از مواد شیمیایی سمی و آلایندهها کمک کرده و تولید داروها را سازگار با محیط زیست میکند.
در نهایت، میتوان گفت که میکروبیولوژی دارویی پلی بین علم و صنعت، بین تحقیق و کاربرد بالینی است. این شاخه علمی با شناسایی و بهرهبرداری از تواناییهای میکروارگانیسمها، امکان تولید داروها و مواد درمانی نوین را فراهم کرده و نقش مهمی در بهبود سلامت عمومی و توسعه فناوریهای دارویی ایفا میکند. به همین دلیل، مطالعه و سرمایهگذاری در این حوزه نه تنها از منظر علمی، بلکه از نظر اقتصادی و اجتماعی نیز بسیار حیاتی است.
میکروارگانیسمها و متابولیتهای دارویی
میکروارگانیسمها از جمله باکتریها، قارچها، جلبکها و سیانوباکتریها، نقش بیبدیلی در تولید متابولیتهای دارویی ایفا میکنند. این موجودات ریز، به دلیل توانایی ذاتی خود در سنتز ترکیبات پیچیده زیستی، توانستهاند جایگاه ویژهای در داروسازی و بیوتکنولوژی پیدا کنند. متابولیتهای دارویی شامل ترکیباتی هستند که فعالیت بیولوژیک دارند و میتوانند به شکل مستقیم یا پس از فرآوری، در درمان بیماریها، مکملهای تغذیهای و داروهای تخصصی مورد استفاده قرار گیرند.
باکتریها بهعنوان کارخانههای بیولوژیک نقش مهمی در تولید داروهای مدرن دارند. گونههای باکتریایی مانند Streptomyces, Bacillus subtilis و Corynebacterium، به دلیل توانایی تولید طیف وسیعی از ترکیبات، به ستون فقرات صنعت دارویی تبدیل شدهاند. Streptomyces به عنوان یکی از مهمترین تولیدکنندگان آنتیبیوتیکها شناخته میشود و قادر است ترکیباتی نظیر استرپتومایسین، تتراسایکلین و اریترومایسین را سنتز کند. علاوه بر آنتیبیوتیکها، برخی باکتریها میتوانند اسیدهای آمینه ضروری، ویتامینها و آنزیمها را در مقیاس صنعتی تولید نمایند، که این امر باعث شده استفاده از باکتریها در صنعت دارویی هم از منظر علمی و هم اقتصادی بسیار ارزشمند باشد.
قارچها نیز به عنوان منابع غنی از ترکیبات بیواکتیو شناخته میشوند. قارچهای رشتهای و مخمرها میتوانند طیف وسیعی از متابولیتهای ثانویه تولید کنند که شامل آنتیبیوتیکها، داروهای ضدسرطان، آنزیمها و ترکیبات ضدالتهاب است. به عنوان مثال، تولید پنیسیلین توسط Penicillium chrysogenum یکی از معروفترین نمونهها است که پایهای برای صنعت آنتیبیوتیکها ایجاد کرده است. علاوه بر آن، برخی قارچها مانند Aspergillus niger و Saccharomyces cerevisiae قادرند ویتامینها و آنزیمهای صنعتی را به شکل پایدار و اقتصادی تولید کنند.
جلبکها و سیانوباکتریها به عنوان منابع نوظهور متابولیتهای دارویی شناخته میشوند. این میکروارگانیسمها قادرند ترکیباتی با فعالیتهای آنتیاکسیدانی، ضدالتهابی و ضدتوموری تولید کنند. جلبکها نه تنها ویتامینها و اسیدهای آمینه ضروری را تامین میکنند، بلکه تولید ترکیبات نانویی و بیواکتیو را نیز امکانپذیر میسازند. به طور خاص، برخی سیانوباکتریها قادر به تولید متابولیتهای نوترکیب با اثرات فارماکولوژیک ویژه هستند که در داروسازی مدرن و تحقیقات بیوتکنولوژیک اهمیت فزایندهای یافتهاند.
علاوه بر این، همزیستهای حشرات نیز به عنوان منابع بالقوه متابولیتهای دارویی مورد توجه قرار گرفتهاند. مطالعات اخیر نشان دادهاند که باکتریها و قارچهای همزیست در دستگاه گوارش حشرات قادرند ترکیباتی تولید کنند که خاصیت ضدباکتریایی، ضدقارچی و حتی آنتیتوموری دارند. این کشف، دریچهای نوین برای بیوتکنولوژی دارویی گشوده است و امکان استفاده از میکروارگانیسمهای کمتر شناخته شده در تولید داروهای طبیعی و ترکیبات نوین را فراهم میآورد.
متابولیتهای دارویی میتوانند به دو دسته اصلی تقسیم شوند: متابولیتهای اولیه و متابولیتهای ثانویه. متابولیتهای اولیه شامل ترکیباتی هستند که برای رشد و بقاء میکروارگانیسم ضروریاند، مانند اسیدهای آمینه، ویتامینها و قندها. این ترکیبات علاوه بر نقش زیستی، در تولید مکملهای تغذیهای و داروهای عملکردی کاربرد دارند. در مقابل، متابولیتهای ثانویه به طور مستقیم برای رشد میکروب ضروری نیستند، اما دارای فعالیتهای بیولوژیکی خاص هستند که شامل آنتیبیوتیکها، سموم ضدتوموری و ترکیبات ضدالتهاب میشود. این دسته از متابولیتها اهمیت بالایی در داروسازی و تحقیقات بالینی دارند، زیرا قادرند مسیرهای درمانی نوین و ترکیبات دارویی با اثرات هدفمند ایجاد کنند.
یکی از نکات کلیدی در مطالعه میکروارگانیسمها و متابولیتهای دارویی، درک مسیرهای متابولیکی و عوامل تنظیمکننده تولید است. تولید متابولیتها تحت تاثیر شرایط محیطی، نوع بستر کشت، pH، دما و وجود عوامل استرسزا قرار دارد. از این رو، تحقیقات علمی بر روی بهینهسازی شرایط کشت و مهندسی مسیرهای بیوسنتزی تمرکز دارند تا تولید داروها در مقیاس صنعتی با بازدهی بالا و هزینه کمتر ممکن شود.
امروزه با بهرهگیری از فناوریهای نوین مانند مهندسی ژنتیک، CRISPR، بیوراکتورها و شبیهسازیهای متابولیک، توانستهایم بهرهوری میکروارگانیسمها را به طور قابل توجهی افزایش دهیم و متابولیتهای دارویی جدید با اثرات بیولوژیکی قوی و ایمنی بالا تولید کنیم. این فناوریها امکان طراحی میکروارگانیسمهای هدفمند را فراهم کردهاند که قادر به تولید ترکیبات دارویی با کیفیت بالا، خلوص مطلوب و مقیاس صنعتی هستند.
در مجموع، میکروارگانیسمها نه تنها منابع طبیعی غنی برای تولید داروهای مدرن و متابولیتهای زیستی هستند، بلکه با استفاده از مهندسی متابولیکی و فناوریهای نوین، میتوان آنها را به کارخانههای زیستی پایدار و اقتصادی تبدیل کرد. این واقعیت اهمیت میکروبیولوژی دارویی را به عنوان یک شاخه علمی حیاتی و بینرشتهای نشان میدهد که با ارتقای سلامت عمومی، توسعه داروهای نوین و بهبود فرآیندهای صنعتی، نقش بسیار مهمی در آینده پزشکی و بیوتکنولوژی ایفا میکند.
تولید آنتیبیوتیکها توسط میکروارگانیسمها
آنتیبیوتیکها از مهمترین متابولیتهای ثانویه میکروارگانیسمها هستند که به طور مستقیم در کنترل و درمان بیماریهای عفونی کاربرد دارند. این ترکیبات زیستی با مهار رشد یا تخریب میکروارگانیسمهای بیماریزا، نقش حیاتی در پزشکی مدرن و بهداشت عمومی ایفا میکنند. تولید آنتیبیوتیکها توسط میکروارگانیسمها نه تنها از نظر علمی اهمیت دارد، بلکه پایهای برای توسعه صنایع دارویی، کاهش هزینه تولید و ارائه داروهای با کیفیت بالا فراهم میآورد.
میکروارگانیسمهای تولیدکننده آنتیبیوتیک عمدتاً شامل گونههای باکتریایی و قارچی هستند. گونههای باکتریایی Streptomyces یکی از شناختهشدهترین منابع تولید آنتیبیوتیکهای تجاری مانند استرپتومایسین، تتراسایکلین و اریترومایسین میباشند. این باکتریها با دارا بودن ژنهای خاص کلاستر متابولیک قادرند مجموعه وسیعی از ترکیبات ضدباکتری تولید کنند. علاوه بر Streptomyces، باکتریهایی مانند Bacillus subtilis و گونههای Corynebacterium نیز در تولید آنتیبیوتیکها و ترکیبات ضدقارچی نقش مهمی دارند. این باکتریها به دلیل سرعت رشد، سازگاری با شرایط کشت صنعتی و توانایی تولید ترکیبات با فعالیت بالا، به ستون فقرات صنعت آنتیبیوتیک تبدیل شدهاند.
قارچها نیز به عنوان منابع اصلی برخی آنتیبیوتیکها شناخته میشوند. شناختهشدهترین مثال، تولید پنیسیلین توسط Penicillium chrysogenum است. این قارچ قادر است تحت شرایط کنترلشده و با بهرهگیری از روشهای مدرن کشت، مقادیر بالایی از پنیسیلین را تولید کند. علاوه بر پنیسیلین، قارچهای دیگر قادر به تولید ترکیباتی با اثرات ضدقارچی، ضدویروسی و ضدتوموری هستند که اهمیت آنها در صنایع دارویی به شدت بالا است.
مکانیسم تولید آنتیبیوتیکها در میکروارگانیسمها پیچیده و تحت تأثیر مسیرهای متابولیکی خاص است. متابولیتهای ثانویه مانند آنتیبیوتیکها معمولاً در مرحله ثانویه رشد میکروارگانیسم تولید میشوند، یعنی زمانی که رشد سلولی به نقطه پایانی نزدیک شده و منابع غذایی محدود میشود. این فرآیند تحت کنترل عوامل ژنتیکی و محیطی است. عوامل محیطی شامل نوع بستر کشت، دما، pH، میزان اکسیژن و وجود یونهای فلزی میباشند که میتوانند به شدت بر میزان تولید تأثیرگذار باشند.
برای افزایش بازده تولید آنتیبیوتیکها، مهندسی متابولیکی و بهینهسازی شرایط کشت به کار گرفته میشود. استفاده از فناوریهایی مانند بیوراکتورهای صنعتی، کشت تعلیقی، تغذیه مرحلهای و افزودن پیشسازهای شیمیایی به رشد میکروارگانیسمها و افزایش تولید ترکیبات دارویی کمک میکند. علاوه بر این، مهندسی ژنتیک امکان دستکاری مسیرهای بیوسنتزی را فراهم میکند تا گونههای میکروبی قادر به تولید آنتیبیوتیک با خلوص بالاتر، بازده بیشتر و ساختار بهینه باشند.
آنتیبیوتیکها به لحاظ شیمیایی و عملکردی به دستههای مختلفی تقسیم میشوند. برخی از مهمترین دستهها عبارتند از:
-
β-لاکتامها: شامل پنیسیلین و سفالوسپورینها، که با مهار سنتز دیواره سلولی باکتریها عمل میکنند.
-
آمینوگلیکوزیدها: مانند استرپتومایسین و جنتامایسین، که موجب اختلال در سنتز پروتئین باکتریایی میشوند.
-
تتراسایکلینها: با مهار ریبوزوم باکتریها، مانع ترجمه پروتئین میشوند.
-
ماکرولیدها: مانند اریترومایسین، که با اتصال به ریبوزوم مانع رشد باکتری میشوند.
تولید صنعتی آنتیبیوتیکها نیازمند کنترل دقیق کیفیت، خلوص و ایمنی محصول است. آنتیبیوتیکها باید در شرایطی تولید شوند که عاری از آلایندهها، باکتریهای مزاحم و ترکیبات سمی باشند. علاوه بر این، میزان و فعالیت بیولوژیک محصول باید با استانداردهای جهانی مطابقت داشته باشد.
یکی از چالشهای مهم در تولید آنتیبیوتیکها، مقاومت دارویی و انتخاب سویههای مقاوم است. این مسئله باعث شده است که تحقیقات بر روی یافتن میکروارگانیسمهای جدید، مسیرهای متابولیکی نوین و ترکیبات با اثرات هدفمند و کمتر مستعد مقاومت افزایش یابد. در این راستا، بیوپروسپکتینگ میکروارگانیسمها از منابع طبیعی و کمتر شناخته شده مانند خاکهای غنی از مواد آلی، جلبکها و همزیستهای حشرات مورد توجه قرار گرفته است.
امروزه، آنتیبیوتیکها نه تنها به شکل سنتی مصرف میشوند، بلکه در ترکیب با داروهای هدفمند، داروهای نانو و داروهای شخصیسازی شده نیز کاربرد دارند. این نوآوریها امکان درمان بهتر، کاهش عوارض جانبی و افزایش کارایی داروها را فراهم میآورند. به علاوه، استفاده از میکروارگانیسمهای تولیدکننده آنتیبیوتیک در صنایع بیوتکنولوژی و داروسازی سفید (White Biotechnology) موجب تولید پایدار و دوستدار محیط زیست شده است.
در نهایت، تولید آنتیبیوتیکها توسط میکروارگانیسمها نمونهای برجسته از توانایی طبیعت در ارائه راهکارهای درمانی پیچیده است. با استفاده از میکروبها به عنوان کارخانههای زیستی، میتوان داروهای مؤثر، ایمن و اقتصادی تولید کرد و همزمان مسیر تحقیقات دارویی نوین را توسعه داد. اهمیت این فرآیند در حفظ سلامت عمومی، مقابله با بیماریهای عفونی و پیشرفت داروسازی غیرقابل انکار است و نشان میدهد که میکروبیولوژی دارویی نقش حیاتی در زندگی انسان ایفا میکند.
تولید ویتامینها با استفاده از میکروارگانیسمها
ویتامینها گروهی از ترکیبات آلی هستند که بدن انسان قادر به سنتز آنها به میزان کافی نیست و باید از منابع غذایی یا مکملهای دارویی تامین شوند. اهمیت ویتامینها در سلامت عمومی، عملکرد سیستم ایمنی، رشد سلولی و متابولیسم انرژی غیرقابل انکار است. با پیشرفت میکروبیولوژی دارویی، تولید ویتامینها با استفاده از میکروارگانیسمها به یکی از مهمترین روشهای صنعتی تبدیل شده است، زیرا این روش هم اقتصادی و پایدار است و هم قادر است ویتامینهایی با خلوص بالا و فعالیت زیستی مطلوب تولید کند.
میکروارگانیسمهایی که در تولید ویتامینها مورد استفاده قرار میگیرند، شامل باکتریها، قارچها و جلبکها هستند. باکتریهایی مانند Corynebacterium glutamicum، Bacillus subtilis و برخی گونههای Lactobacillus در تولید ویتامینهای گروه B، به ویژه ریبوفلاوین (B2)، نیاسین (B3)، تیامین (B1) و اسید پانتوتنیک (B5) نقش اساسی دارند. این باکتریها با استفاده از مسیرهای بیوسنتزی خود، قادر به تولید ویتامینها در مقیاس صنعتی هستند. برای مثال، مهندسی ژنتیک Corynebacterium glutamicum موجب افزایش تولید ریبوفلاوین تا سطح تجاری شده است و یکی از مهمترین منابع صنعتی ویتامین B2 محسوب میشود.
قارچها نیز در تولید ویتامینها کاربرد دارند. Saccharomyces cerevisiae (مخمر نان و آبجو) قادر است ویتامینهای گروه B، به ویژه نیاسین و تیامین، را تولید کند. علاوه بر این، مخمرها قادر به تولید ویتامین D2 (ارگوکلسیفرول) هستند، که اهمیت ویژهای در سلامت استخوانها و متابولیسم کلسیم دارد. استفاده از قارچها برای تولید ویتامینها مزیتهایی نظیر سنتز طبیعی، سازگاری با محیط زیست و کاهش هزینههای تولید دارد.
جلبکها و سیانوباکتریها نیز به عنوان منابع نوظهور ویتامینها مورد توجه قرار گرفتهاند. برخی جلبکها قادرند ویتامین C، ویتامین E و کاروتنوئیدها را تولید کنند که دارای فعالیت آنتیاکسیدانی و محافظتکننده سلولی هستند. این ترکیبات علاوه بر کاربردهای دارویی، در صنایع مکملهای غذایی، نوشیدنیهای سلامت و محصولات ضدپیری نیز استفاده میشوند. از جمله، جلبکهای میکروسکوپی مانند Chlorella vulgaris و Spirulina platensis منابع غنی ویتامینهای محلول در آب و محلول در چربی محسوب میشوند.
مسیرهای بیوسنتزی و بهینهسازی تولید ویتامینها از نکات کلیدی در این حوزه است. تولید ویتامینها تحت تاثیر عوامل محیطی مانند نوع بستر کشت، دما، pH، غلظت اکسیژن و حضور پیشسازهای متابولیکی است. با استفاده از مهندسی متابولیکی، میتوان مسیرهای سنتز ویتامینها را در میکروارگانیسمها افزایش داد، بازده تولید را بهبود بخشید و ترکیبات با فعالیت زیستی بالاتر تولید کرد. به عنوان مثال، افزودن پیشسازهای شیمیایی به محیط کشت یا دستکاری ژنهای کلیدی مسیر، میتواند تولید ریبوفلاوین، نیاسین یا تیامین را چندین برابر افزایش دهد.
استفاده از میکروارگانیسمها برای تولید ویتامینها، علاوه بر مزایای اقتصادی و بهرهوری بالا، با پایداری محیط زیستی نیز همخوانی دارد. تولید ویتامینها با روشهای شیمیایی اغلب نیازمند مواد اولیه سمی و انرژی زیاد است، در حالی که تولید میکروبی با بهرهگیری از منابع طبیعی، ضایعات کشاورزی و محیطهای کمهزینه، فرآیندی سبز و پایدار فراهم میکند. در برخی موارد، ضایعات صنعتی و کشاورزی به عنوان بستر برای رشد میکروارگانیسمها و تولید ویتامینها مورد استفاده قرار میگیرند، که نمونهای از اقتصادیسازی و همافزایی صنعت و محیط زیست محسوب میشود.
ویتامینهای تولید شده توسط میکروارگانیسمها نه تنها در صنایع غذایی و دارویی کاربرد دارند، بلکه در بهبود سلامت حیوانات و تولید مکملهای تغذیهای نیز نقش دارند. تحقیقات نشان داده است که افزودن ویتامینهای میکروبی به خوراک دام و طیور، علاوه بر افزایش رشد و عملکرد، موجب تقویت سیستم ایمنی و کاهش نیاز به آنتیبیوتیکها میشود. این موضوع اهمیت ویتامینهای میکروبی را در زمینه سلامت عمومی و تولید پایدار غذا برجسته میسازد.
چالشها و راهکارها در تولید ویتامینهای میکروبی شامل کنترل کیفیت، تثبیت محصول، جلوگیری از آلودگی و حفظ فعالیت زیستی ترکیبات است. ویتامینها به ویژه ویتامینهای محلول در آب، حساس به حرارت و نور هستند و نیاز به شرایط ذخیرهسازی مناسب دارند. برای رفع این چالشها، استفاده از فرآیندهای خشکسازی، کپسولهسازی و ترکیب با حاملهای مناسب توصیه میشود. همچنین، ترکیب مهندسی متابولیکی با فناوریهای کشت پیشرفته، امکان تولید ویتامینهای با خلوص بالا و فعالیت بیولوژیک مطلوب را فراهم کرده است.
در نهایت، تولید ویتامینها با استفاده از میکروارگانیسمها نمونهای از همافزایی علم، صنعت و طبیعت است. این روش تولید نه تنها امکان دسترسی به ترکیبات دارویی و مکملهای غذایی با کیفیت بالا را فراهم میکند، بلکه مسیر را برای توسعه داروهای نوین، محصولات تغذیهای و سلامت محور هموار میسازد. اهمیت این فرآیند در سلامت عمومی، صنعت داروسازی و صنایع غذایی، به ویژه در زمینه تولید پایدار و اقتصادی، بسیار چشمگیر است و نشان میدهد که میکروبیولوژی دارویی قادر است تحولات بنیادی در بهبود کیفیت زندگی و سلامت انسان ایجاد کند.
تولید آنزیمهای دارویی و صنعتی توسط میکروارگانیسمها
آنزیمها، پروتئینهای زیستی با فعالیت کاتالیتیکی هستند که در فرآیندهای بیوشیمیایی بدن و صنایع مختلف نقش حیاتی ایفا میکنند. در صنعت داروسازی، آنزیمها به عنوان بیوکاتالیزورهای طبیعی برای سنتز داروها، اصلاح ترکیبات فعال و تولید داروهای با کیفیت بالا مورد استفاده قرار میگیرند. مزیت اصلی استفاده از آنزیمها، توانایی آنها در انجام واکنشهای شیمیایی با سازگاری زیستی بالا، بازدهی زیاد و عوارض جانبی کم است.
میکروارگانیسمها، به ویژه باکتریها، قارچها و جلبکها، منابع اصلی تولید آنزیمهای صنعتی و دارویی محسوب میشوند. گونههایی مانند Bacillus subtilis، Aspergillus niger و Saccharomyces cerevisiae توانایی تولید طیف گستردهای از آنزیمها را دارند که شامل پروتئازها، لیپازها، آمیلازها، سلولازها و ترانسگلوکوزیلازها میشوند. این آنزیمها در سنتز داروهای فعال، هضم ترکیبات پیچیده و تولید مکملهای تغذیهای کاربرد دارند.
کاربرد آنزیمها در داروسازی و پزشکی بسیار گسترده است. برخی از آنزیمها به عنوان داروهای مستقیم مورد استفاده قرار میگیرند، مانند آنزیمهای پانکراس که در درمان اختلالات گوارشی به کار میروند، یا ترومبولیتیکها که در درمان لختههای خونی مورد استفاده قرار میگیرند. علاوه بر این، آنزیمها به عنوان ابزارهای صنعتی برای سنتز ترکیبات دارویی، اصلاح ساختار مولکولی و تولید پروبیوتیکها کاربرد دارند. این کاربردها نشان میدهند که آنزیمها نه تنها در سطح مولکولی، بلکه در بهبود سلامت و کارایی داروها نقش تعیینکنندهای دارند.
تولید آنزیمها توسط میکروارگانیسمها عمدتاً از طریق دو روش کشت انجام میشود: کشت در حالت مایع (Submerged Fermentation) و کشت در حالت جامد (Solid-State Fermentation). در کشت مایع، میکروارگانیسمها در محیطهای آبی با منابع غذایی کنترلشده رشد میکنند و آنزیمها به صورت ترشحی یا سلولی تولید میشوند. این روش امکان کنترل دقیق شرایط محیطی مانند دما، pH و اکسیژن را فراهم میکند و برای تولید صنعتی آنزیمها مناسب است. در مقابل، کشت در حالت جامد بر روی بسترهای طبیعی یا ضایعات کشاورزی انجام میشود و به دلیل هزینه کمتر و بازدهی بالا، برای تولید برخی آنزیمها کاربرد دارد.
بهینهسازی تولید آنزیمها شامل عوامل محیطی و ژنتیکی است. عوامل محیطی شامل دمای مناسب، pH، ترکیب مواد مغذی و تهویه مناسب میشوند، در حالی که عوامل ژنتیکی با دستکاری مسیرهای بیوسنتزی و انتخاب سویههای پرتوان به افزایش تولید کمک میکنند. به عنوان مثال، مهندسی ژنتیک Bacillus subtilis موجب افزایش تولید پروتئازها و لیپازها شده و امکان تولید آنزیمهای با خلوص و فعالیت بالا را فراهم کرده است.
از دیگر مزایای استفاده از میکروارگانیسمها برای تولید آنزیمها، سازگاری با محیط زیست و کاهش استفاده از مواد شیمیایی سمی است. سنتز شیمیایی آنزیمها به دلیل نیاز به شرایط سخت و واکنشهای شیمیایی پیچیده، اغلب هزینهبر و آلاینده است، در حالی که میکروارگانیسمها قادرند همان ترکیبات را با مصرف انرژی کمتر و تولید ضایعات کمتر تولید کنند.
یکی از نکات مهم در استفاده از آنزیمهای دارویی، تثبیت و نگهداری فعالیت آنزیمها است. آنزیمها حساس به دما، نور و pH هستند و برای حفظ فعالیت بیولوژیک آنها نیاز به فرآیندهای خشکسازی، کپسولهسازی و افزودن تثبیتکنندهها وجود دارد. این اقدامات به ویژه برای تولید داروهای آنزیمی و مکملهای غذایی اهمیت دارد تا محصول نهایی دارای فعالیت بالا و طول عمر مفید مناسب باشد.
علاوه بر تولید آنزیمهای طبیعی، بیوتکنولوژی مدرن امکان طراحی آنزیمهای نوترکیب را فراهم کرده است. با استفاده از تکنیکهای مهندسی ژنتیک، میتوان آنزیمهایی با ویژگیهای خاص طراحی کرد که واکنشهای پیچیده را در شرایط کنترلشده انجام دهند و بازدهی تولید داروها را افزایش دهند. این روشها باعث شدهاند که آنزیمها به عنوان ابزارهای کلیدی در تولید داروهای نوین و بیومواد شناخته شوند.
کاربرد آنزیمها در صنایع مختلف فراتر از داروسازی است. آنها در تولید مکملهای غذایی، پروبیوتیکها، محصولات ضدالتهابی و آنتیاکسیدانی، و حتی در تولید بیومواد و نانوذرات کاربرد دارند. این گستردگی کاربرد، اهمیت تولید آنزیمها توسط میکروارگانیسمها را نشان میدهد و دلیل اصلی تمرکز صنایع بر روی بهینهسازی فرآیندهای تولید آنها است.
در نهایت، تولید آنزیمها توسط میکروارگانیسمها نمونهای از همافزایی علم و فناوری است که امکان تولید داروها و ترکیبات با کیفیت بالا را فراهم میکند. با به کارگیری میکروارگانیسمها به عنوان کارخانههای زیستی طبیعی، میتوان فرآیندهای صنعتی و دارویی را اقتصادی، پایدار و سازگار با محیط زیست انجام داد و همزمان نوآوریهای دارویی و تحقیقاتی را ارتقا داد. اهمیت این فرآیند در بهبود سلامت، تولید داروهای با کیفیت و توسعه بیوتکنولوژی صنعتی غیرقابل انکار است.
فناوریهای نوین در میکروبیولوژی دارویی
میکروبیولوژی دارویی در دهههای اخیر با ورود فناوریهای نوین تحول عظیمی یافته است. فناوریهای مدرن امکان شناسایی، مهندسی و بهرهبرداری از میکروارگانیسمها برای تولید داروها، ویتامینها و آنزیمها را فراهم کردهاند. این تحولات به صنایع دارویی کمک میکند تا محصولات با کیفیت، خلوص بالا و کارایی بیولوژیک بهتری تولید کنند و همزمان هزینهها و اثرات زیستمحیطی را کاهش دهند.
یکی از مهمترین فناوریهای نوین، مهندسی ژنتیک و مهندسی متابولیکی است. با استفاده از این فناوری، مسیرهای بیوسنتزی میکروارگانیسمها قابل دستکاری هستند تا تولید متابولیتهای دارویی مانند آنتیبیوتیکها، ویتامینها و آنزیمها به حداکثر برسد. به عنوان مثال، با دستکاری ژنهای کلیدی در Streptomyces، میتوان تولید آنتیبیوتیکهایی نظیر تتراسایکلین و اریترومایسین را افزایش داد. همچنین، مهندسی مسیرهای متابولیکی در باکتریهای تولیدکننده ویتامینها باعث افزایش چشمگیر تولید ریبوفلاوین و نیاسین شده است.
بیوراکتورهای پیشرفته و فناوری کشت کنترلشده از دیگر فناوریهای نوین هستند که تولید میکروبی را بهینه میکنند. بیوراکتورها امکان کنترل دقیق پارامترهایی مانند دمای محیط، pH، میزان اکسیژن، سرعت همزن و غلظت مواد مغذی را فراهم میآورند. این کنترل دقیق باعث افزایش بازده تولید، کیفیت محصول و کاهش زمان فرآیند میشود. همچنین، استفاده از کشت تعلیقی، تغذیه مرحلهای و بسترهای جامد بهینهشده موجب میشود میکروارگانیسمها در شرایط نزدیک به طبیعی و با بازدهی بالا فعالیت کنند.
یکی دیگر از فناوریهای نوین، بیوپروسپکتینگ و کشف میکروارگانیسمهای کمتر شناخته شده است. این رویکرد شامل شناسایی میکروبها از منابع طبیعی مانند خاکهای غنی، جلبکها، سیانوباکتریها و همزیستهای حشرات است. با این روش، میتوان ترکیبات دارویی نوین با اثرات ضدباکتری، ضدویروسی و ضدتوموری پیدا کرد که در میکروبهای شناختهشده وجود ندارند. بیوپروسپکتینگ باعث توسعه داروهای نوین، مکملهای تغذیهای و ترکیبات ضدالتهابی میشود و امکان تولید ترکیبات با فعالیت بیولوژیک ویژه را فراهم میآورد.
زیستفناوری سفید (White Biotechnology) نیز نقش بسیار مهمی در میکروبیولوژی دارویی ایفا میکند. این فناوری با هدف تولید محصولات بیولوژیک با دوستدار محیط زیست، پایدار و اقتصادی توسعه یافته است. در زیستفناوری سفید، میکروارگانیسمها به عنوان کارخانههای زیستی طبیعی برای تولید آنتیبیوتیکها، ویتامینها، آنزیمها و ترکیبات دارویی استفاده میشوند. این رویکرد باعث کاهش مصرف مواد شیمیایی سمی، انرژی و تولید ضایعات صنعتی میشود و فرآیند تولید را هم از نظر اقتصادی و هم از نظر زیستمحیطی بهینه میکند.
فناوریهای نوین همچنین شامل مهندسی آنزیمها و طراحی پروتئینهای نوترکیب است. با این فناوری، میتوان آنزیمهایی با ویژگیهای خاص، پایداری بالا و بازدهی بهینه تولید کرد. این آنزیمها در تولید داروهای فعال، سنتز ترکیبات پیچیده و اصلاح مولکولی به کار میروند و امکان تولید محصولات دارویی با کیفیت و خلوص بالاتر را فراهم میآورند.
یکی دیگر از نوآوریها، استفاده از نانوبیوتکنولوژی و حاملهای نانو برای تحویل داروها و آنزیمها است. این فناوری امکان میدهد ترکیبات دارویی یا آنزیمی به صورت کنترلشده و هدفمند به محل مورد نظر بدن منتقل شوند. استفاده از نانوذرات، میکروکپسولها و حاملهای زیستی باعث افزایش کارایی دارو، کاهش عوارض جانبی و حفظ فعالیت بیولوژیک میشود.
تحلیل دادهها و شبیهسازیهای متابولیک نیز از فناوریهای کلیدی در میکروبیولوژی دارویی محسوب میشوند. با استفاده از نرمافزارهای شبیهسازی، میتوان مسیرهای متابولیکی میکروارگانیسمها را بررسی کرد، نقاط محدودکننده تولید را شناسایی نمود و فرآیند تولید را بهینهسازی کرد. این روشها امکان پیشبینی میزان تولید، کاهش خطاهای صنعتی و افزایش بازده داروها را فراهم میکنند.
فناوریهای نوین همچنین شامل تولید ترکیبات دارویی نوین از جلبکها و سیانوباکتریها است. این میکروارگانیسمها قادر به تولید متابولیتهایی با اثرات آنتیاکسیدانی، ضدالتهابی، ضدسرطانی و ضدباکتریایی هستند. با استفاده از مهندسی ژنتیک و فناوریهای کشت پیشرفته، میتوان این ترکیبات را به شکل ثابت، پایدار و اقتصادی تولید کرد و در صنایع دارویی و مکملهای تغذیهای استفاده نمود.
در نهایت، فناوریهای نوین در میکروبیولوژی دارویی نشان میدهند که ترکیب علم، فناوری و طبیعت میتواند تولید داروها، ویتامینها و آنزیمها را به سطحی کاملاً پایدار، اقتصادی و کارآمد برساند. این تحولات نه تنها به توسعه صنایع دارویی و سلامت محور کمک میکنند، بلکه مسیر را برای نوآوریهای آینده در تولید داروهای هدفمند و ترکیبات زیستی نوین هموار میکنند. اهمیت این فناوریها در بهبود کیفیت زندگی، کاهش هزینههای تولید و ارتقای سلامت عمومی غیرقابل انکار است و نشان میدهد که میکروبیولوژی دارویی در قرن بیست و یکم به یک حوزه پیشرو و حیاتی تبدیل شده است.
چالشها و محدودیتهای تولید دارو با میکروارگانیسمها
تولید داروها، ویتامینها و آنزیمها با استفاده از میکروارگانیسمها، هرچند نوآورانه و کارآمد است، اما با چالشها و محدودیتهای متعددی روبهرو میباشد. شناخت این محدودیتها برای بهینهسازی فرآیندهای تولید، کاهش هزینهها و افزایش کیفیت محصولات ضروری است.
یکی از مهمترین چالشها، تنوع و پیچیدگی مسیرهای متابولیکی میکروارگانیسمها است. تولید متابولیتهای دارویی مانند آنتیبیوتیکها و ویتامینها به مسیرهای بیوسنتزی خاص وابسته است که تحت کنترل دقیق ژنتیکی و محیطی قرار دارند. هرگونه تغییر کوچک در شرایط کشت میتواند منجر به کاهش تولید، تغییر کیفیت محصول یا ایجاد ترکیبات جانبی نامطلوب شود. به عنوان مثال، مسیرهای تولید آنتیبیوتیکها در Streptomyces به شدت به دما، pH، میزان اکسیژن و ترکیب مواد مغذی حساس هستند. این حساسیت باعث میشود کنترل فرآیند تولید در مقیاس صنعتی بسیار پیچیده و نیازمند نظارت دقیق باشد.
سویههای میکروبی مقاوم یا ناکارآمد نیز یکی دیگر از چالشهای اساسی محسوب میشوند. انتخاب سویههای مناسب برای تولید داروها نیازمند بررسیهای گسترده ژنتیکی و فیزیولوژیکی است. بسیاری از سویههای طبیعی توانایی تولید کافی ترکیبات دارویی را ندارند و سویههای مهندسیشده ممکن است در شرایط صنعتی عملکرد مطلوب نداشته باشند. علاوه بر این، احتمال ایجاد سویههای مقاوم یا آلودهکننده در محیطهای کشت صنعتی وجود دارد که میتواند تولید را مختل کند و سلامت محصول را تهدید نماید.
کنترل کیفیت و ایمنی محصول یکی از بزرگترین محدودیتها در تولید دارو با میکروارگانیسمها است. آلودگیهای میکروبی یا ترکیبات سمی جانبی میتوانند فعالیت زیستی محصول را کاهش دهند و حتی خطرات سلامت عمومی ایجاد کنند. تولید صنعتی نیازمند سیستمهای کنترل کیفیت دقیق، آزمایشهای مکرر و استانداردهای بینالمللی است تا اطمینان حاصل شود محصول نهایی دارای خلوص بالا، فعالیت بیولوژیک مناسب و ایمنی کافی باشد.
یکی دیگر از محدودیتهای مهم، مقیاسپذیری فرآیند تولید است. بسیاری از فرآیندهای تولید که در مقیاس آزمایشگاهی موفق هستند، در مقیاس صنعتی با مشکلاتی مانند عدم توزیع یکنواخت مواد مغذی، اکسیژنرسانی ناکافی، کنترل دما و تولید محصولات جانبی مواجه میشوند. این چالشها مستلزم بهینهسازی بیوقفه فرآیند، استفاده از بیوراکتورهای پیشرفته و طراحی سیستمهای کشت پیچیده است تا تولید پایدار و اقتصادی حاصل شود.
هزینه تولید و اقتصادی بودن فرآیند نیز محدودیت مهمی است. تولید دارو، ویتامین و آنزیم با استفاده از میکروارگانیسمها نیازمند سرمایهگذاری بالا در زمینه تجهیزات، بیوراکتورها، کنترل کیفیت و نیروی انسانی متخصص است. علاوه بر این، برخی میکروارگانیسمها نیازمند بسترهای غذایی گران قیمت یا شرایط خاص محیطی هستند که هزینه تولید را افزایش میدهد. توسعه فناوریهای کشت مبتنی بر ضایعات کشاورزی و منابع کمهزینه میتواند بخشی از این مشکل را کاهش دهد، اما بهینهسازی کامل نیازمند تحقیق و توسعه مداوم است.
ثبات و پایداری محصول نیز یک چالش حیاتی است. آنزیمها و ویتامینها حساس به دما، نور و شرایط شیمیایی هستند و در طول ذخیرهسازی یا حمل و نقل ممکن است فعالیت خود را از دست بدهند. برای رفع این مشکل، فرآیندهایی مانند خشکسازی انجمادی، کپسولهسازی و افزودن تثبیتکنندهها استفاده میشوند، اما این اقدامات خود هزینه و پیچیدگی فرآیند را افزایش میدهند.
مسائل زیستمحیطی و ایمنی زیستی نیز محدودیتهای تولید میکروبی را تشدید میکنند. استفاده از سویههای مهندسیشده ژنتیکی و تولید متابولیتهای فعال، نیازمند سیستمهای ایمنی زیستی دقیق است تا ریسک فرار میکروبها یا آلودگی محیطی به حداقل برسد. علاوه بر این، فرآیندهای صنعتی میتوانند مصرف آب، انرژی و تولید ضایعات را افزایش دهند که ضرورت توسعه روشهای سبز و پایدار را پررنگ میکند.
مقاومت دارویی و اثرات جانبی بالقوه نیز چالشهای مهم در تولید آنتیبیوتیکها و متابولیتهای دارویی هستند. استفاده مداوم و گسترده از داروهای تولید شده توسط میکروارگانیسمها میتواند منجر به ظهور سویههای مقاوم شود و بازده درمانی داروها را کاهش دهد. این موضوع باعث شده است که تحقیقات روی سویههای جدید، ترکیبات نوین و فناوریهای ترکیبی دارویی افزایش یابد تا مقاومت دارویی کنترل شود.
علاوه بر محدودیتهای فنی، محدودیتهای قانونی و مقررات بینالمللی نیز بر تولید داروها اثر میگذارند. فرآیندهای تولید میکروبی باید مطابق با استانداردهای GMP (Good Manufacturing Practice) و سایر مقررات سختگیرانه باشند. رعایت این مقررات، زمان و هزینه تولید را افزایش میدهد، اما تضمینکننده ایمنی و کیفیت محصولات دارویی است.
در نهایت، تولید دارو با میکروارگانیسمها با وجود مزایای علمی و اقتصادی، با مجموعهای از چالشهای علمی، صنعتی، اقتصادی و زیستمحیطی مواجه است. شناسایی، درک و مدیریت این محدودیتها کلید موفقیت در تولید پایدار و موثر داروها، ویتامینها و آنزیمها است. پیشرفت در مهندسی متابولیک، فناوریهای بیوراکتوری، زیستفناوری سفید و بیوپروسپکتینگ به کاهش این محدودیتها کمک کرده و مسیر را برای توسعه داروهای نوین و ترکیبات بیولوژیک با کیفیت بالا هموار میسازد.
چشمانداز آینده و تحقیقات نوین در میکروبیولوژی دارویی
میکروبیولوژی دارویی، به عنوان شاخهای از علوم زیستی که بر استفاده از میکروارگانیسمها برای تولید ترکیبات دارویی، ویتامینها و آنزیمها متمرکز است، در حال تحول سریع است. چشمانداز آینده این حوزه با ادغام فناوریهای نوین، مهندسی متابولیک پیشرفته، هوش مصنوعی و زیستفناوری سفید شکل میگیرد و پتانسیل ایجاد تحولات بنیادی در صنایع دارویی و غذایی را دارد.
یکی از مهمترین روندهای تحقیقاتی، استفاده گسترده از مهندسی ژنتیک و ویرایش ژنومی دقیق است. با ظهور فناوریهایی مانند CRISPR-Cas، امکان دستکاری دقیق ژنوم میکروارگانیسمها فراهم شده است. این فناوری اجازه میدهد مسیرهای متابولیکی برای تولید آنتیبیوتیکها، ویتامینها و آنزیمها بهینه شود، تولید محصولات جانبی کاهش یابد و بازده داروها به حداکثر برسد. در آینده نزدیک، ترکیب این فناوری با بیوانفورماتیک و شبیهسازی متابولیک میتواند به تولید سویههای میکروبی با کارایی فوقالعاده منجر شود که قادر به تولید داروها و ترکیبات پیچیده در مقیاس صنعتی هستند.
بیوپروسپکتینگ پیشرفته و کشف منابع جدید میکروبی نیز بخش کلیدی تحقیقات نوین است. منابع کمتر شناخته شده مانند میكروبیومهای خاکهای قطبی، همزیستهای دریایی و میکروبهای همزیست حشرات میتوانند ترکیبات دارویی نوآورانهای تولید کنند که تا کنون در میکروبهای سنتی یافت نشدهاند. این روند باعث توسعه داروهای ضدسرطان، آنتیبیوتیکهای نوین و مکملهای تغذیهای با اثرات ویژه میشود.
زیستفناوری سفید و تولید پایدار داروها نیز در آینده نقش حیاتی خواهد داشت. با استفاده از فناوریهای سبز، میتوان فرآیندهای تولید دارو، ویتامین و آنزیم را با مصرف انرژی کمتر، کاهش ضایعات صنعتی و سازگاری محیطی بیشتر انجام داد. توسعه بسترهای کشت مبتنی بر ضایعات کشاورزی و صنعتی، استفاده از منابع تجدیدپذیر و طراحی فرآیندهای کمهزینه، چشمانداز تولید پایدار و اقتصادی داروها را ممکن میسازد.
فناوریهای نانو و سیستمهای تحویل هدفمند دارو نیز به سرعت در حال گسترش هستند. استفاده از نانوذرات، میکروکپسولها و حاملهای زیستی میتواند ترکیبات دارویی و آنزیمی را به محل هدف در بدن هدایت کند و فعالیت بیولوژیک آنها را افزایش دهد. این فناوری، نه تنها بازده درمانی را افزایش میدهد، بلکه عوارض جانبی داروها را کاهش داده و امکان تولید داروهای شخصیسازیشده را فراهم میکند.
هوش مصنوعی و یادگیری ماشین در بهینهسازی فرآیندهای تولید و طراحی دارو نقش مهمی خواهند داشت. این فناوریها قادرند الگوهای پیچیده مسیرهای متابولیکی، شرایط کشت و تولید ترکیبات فعال را تحلیل کنند و راهکارهای بهینه برای افزایش بازده و کیفیت محصولات ارائه دهند. همچنین، استفاده از دادههای بزرگ و الگوریتمهای پیشبینی، شناسایی ترکیبات جدید و بهینهسازی فرآیندهای صنعتی را سریعتر و دقیقتر میکند.
توسعه داروهای نوین و ترکیبات چندمنظوره نیز بخش مهمی از چشمانداز آینده است. میکروارگانیسمها قادرند ترکیباتی با فعالیت چندگانه ضدباکتری، ضدویروسی و ضدسرطانی تولید کنند که در درمان بیماریهای پیچیده و مقاوم به درمان کاربرد دارند. ترکیب این رویکرد با فناوریهای مهندسی پروتئین و طراحی مسیرهای متابولیک، امکان تولید داروهای ترکیبی با اثربخشی بالاتر و عوارض جانبی کمتر را فراهم میآورد.
در حوزه ویتامینها و مکملهای تغذیهای، تحقیقات نوین بر روی سویههای میکروبی پرتوان، مهندسی مسیرهای بیوسنتزی و تولید ترکیبات پایدار با فعالیت زیستی بالا متمرکز شده است. این روند میتواند دسترسی به ویتامینها و مواد مغذی با کیفیت بالا و هزینه کمتر را در سطح جهانی تسهیل کند.
در نهایت، ادغام فناوریهای نوین با رویکردهای پایدار و اقتصاد سبز چشمانداز آینده میکروبیولوژی دارویی را شکل میدهد. این حوزه نه تنها در تولید داروهای سنتی و مکملهای غذایی پیشرفت میکند، بلکه مسیر را برای نوآوری در داروهای هدفمند، درمانهای شخصیسازیشده و محصولات زیستی با اثرات ویژه هموار میسازد. تحقیقات نوین و فناوریهای آینده این امکان را فراهم میکنند که میکروارگانیسمها به منابع قدرتمند و قابل اعتماد داروهای نوین و ترکیبات بیولوژیک تبدیل شوند و تاثیر بسزایی بر سلامت انسان و صنایع دارویی داشته باشند.
جمعبندی و نتیجهگیری
میکروبیولوژی دارویی به عنوان یکی از حوزههای پیشرو در علوم زیستی، نشان داده است که میکروارگانیسمها میتوانند منابعی بینظیر برای تولید داروها، ویتامینها و آنزیمها باشند. این حوزه، تلفیقی از علوم پایه، مهندسی زیستی و فناوریهای نوین است که با بهرهگیری از توان طبیعی میکروبها، امکان تولید محصولات دارویی با کیفیت بالا، کارایی زیستی بهینه و اثرات جانبی کمتر را فراهم میکند.
در طول این مقاله بررسی شد که میکروارگانیسمها و متابولیتهای آنها چه نقش کلیدی در تولید ترکیبات دارویی دارند و چگونه میتوان با استفاده از باکتریها، قارچها، جلبکها و سیانوباکتریها، انواع آنتیبیوتیکها، ویتامینها و آنزیمهای صنعتی و دارویی را تولید کرد. بهطور خاص، گونههایی مانند Streptomyces, Bacillus subtilis, Aspergillus niger و Saccharomyces cerevisiae به عنوان منابع اصلی تولید آنتیبیوتیکها و آنزیمها شناخته شدند، و کاربردهای صنعتی و بالینی آنها مورد تحلیل قرار گرفت.
تولید آنتیبیوتیکها توسط میکروارگانیسمها به صورت بیوسنتزی، یکی از موفقترین نمونههای کاربرد میکروبها در داروسازی است. این فرآیندها نه تنها منجر به تولید داروهای مؤثر و با خلوص بالا شدهاند، بلکه امکان مهندسی مسیرهای متابولیکی برای افزایش بازده و تولید ترکیبات جدید را نیز فراهم کردهاند. آنتیبیوتیکها به عنوان ابزارهای اصلی مقابله با عفونتها، همچنان بخش حیاتی سیستمهای درمانی محسوب میشوند و استفاده از میکروارگانیسمها، پایدار و اقتصادی بودن تولید آنها را تضمین میکند.
تولید ویتامینها و مکملهای تغذیهای نیز یکی دیگر از زمینههای کلیدی میکروبیولوژی دارویی است. با استفاده از سویههای پرتوان و مسیرهای مهندسیشده، میتوان ویتامینهای گروه B، ویتامین C و سایر مواد مغذی با فعالیت زیستی بالا و هزینه کمتر تولید کرد. این فرآیندها نه تنها برای صنعت داروسازی، بلکه برای صنایع غذایی و مکملهای سلامت محور اهمیت دارند و به بهبود تغذیه و سلامت جامعه کمک میکنند.
تولید آنزیمهای دارویی و صنعتی نشان میدهد که میکروارگانیسمها میتوانند به عنوان بیوکاتالیزورهای طبیعی، جایگزین واکنشهای شیمیایی پرهزینه و آلاینده شوند. آنزیمها در تولید داروهای فعال، اصلاح ترکیبات شیمیایی، تولید پروبیوتیکها و حتی در سنتز ترکیبات پیچیده کاربرد دارند. فناوریهای نوین امکان طراحی آنزیمهای مهندسیشده با پایداری و فعالیت بالا را فراهم کردهاند و بدین ترتیب بازده و کیفیت محصولات دارویی بهطور چشمگیری افزایش یافته است.
فناوریهای نوین مانند مهندسی ژنتیک، زیستفناوری سفید، بیوپروسپکتینگ، فناوری نانو و هوش مصنوعی، مسیر تولید داروهای نوین را دگرگون کردهاند. این فناوریها امکان بهینهسازی مسیرهای متابولیکی، افزایش بازده، کاهش ضایعات صنعتی و تولید داروهای شخصیسازیشده را فراهم میآورند. استفاده از سویههای میکروبی کمتر شناخته شده، سیستمهای تحویل هدفمند دارو و حاملهای نانو، افقهای تازهای برای تولید داروهای پیچیده و ترکیبات چندمنظوره ایجاد کرده است.
با وجود مزایا و پیشرفتهای چشمگیر، چالشها و محدودیتها همچنان در مسیر تولید دارو با میکروارگانیسمها وجود دارد. حساسیت مسیرهای متابولیکی، انتخاب سویههای مناسب، کنترل کیفیت و ایمنی، مقیاسپذیری، هزینههای تولید و مسائل زیستمحیطی از جمله محدودیتهای مهم هستند. شناسایی و مدیریت این محدودیتها با استفاده از فناوریهای نوین و مهندسی زیستی، کلید موفقیت در تولید پایدار و موثر داروها و ترکیبات بیولوژیک است.
چشمانداز آینده میکروبیولوژی دارویی روشن و امیدوارکننده است. با ادغام فناوریهای پیشرفته و پایدار، میکروارگانیسمها میتوانند به منابع مطمئن و قابل اعتماد داروهای نوین، مکملهای غذایی و ترکیبات صنعتی تبدیل شوند. تحقیقات نوین نشان میدهد که بهبود سلامت، تولید داروهای هدفمند و توسعه محصولات زیستی نوآورانه از طریق میکروبها امکانپذیر است و میتواند تحول قابل توجهی در صنایع دارویی و سلامت جهانی ایجاد کند.
در نتیجه، میکروبیولوژی دارویی نه تنها یک حوزه علمی، بلکه یک فرصت استراتژیک برای صنایع دارویی، غذایی و سلامت محور محسوب میشود. استفاده از میکروارگانیسمها به عنوان منابع طبیعی و قابل مهندسی، هم مزیت اقتصادی دارد، هم مزیت زیستمحیطی و هم امکان تولید محصولات دارویی با کیفیت و کارایی بالا را فراهم میکند. موفقیت در این حوزه مستلزم ترکیب تحقیقات پایه، فناوری نوین، مهندسی زیستی و مدیریت صنعتی است تا مسیر تولید داروهای نوین، ویتامینها و آنزیمها با بازده بالا و پایدار ادامه یابد.




